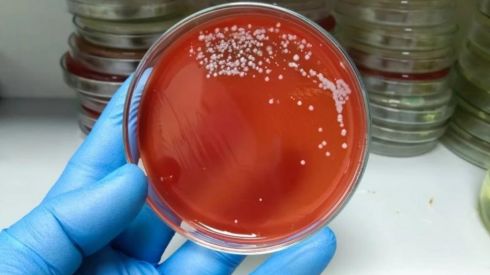
«М’ясоїдна бактерія»: світом шириться смертельна хвороба

У Японії – спалах захворювання, що вбиває третину хворих
У Японії поширюється нова смертельна бактеріальна інфекція.

З кожним днем у Японії фіксують все більше випадків небезпечної інфекції. Сьогодні вже більше 500 людей захворіли на «стрептококовий синдром токсичного шоку» (STSS), повідомляє The Guardian. Фахівці не знають точних причин, чому ця інфекція викликає серйозні ускладнення і прогнозують подальше збільшення захворюваності.
STSS – це смертельно небезпечна інфекція бактеріального походження, що може закінчитися летально для 30% тих, хто нею заразився.
«Причини тяжких та несподіваних проявів стрептококової інфекції залишаються невідомими, і ми поки що не можемо це повноцінно пояснити», – кажуть у Національному інституті боротьби з інфекційними захворюваннями.
Люди, що стикнулися зі «стрептококовим синдромом токсичного шоку», зазвичай мають симптоми ГРЗ (підвищення температури тіла, біль у горлі, загальну слабкість). Найбільш вразливими до ускладнень STSS є люди похилого віку – бактерія може викликати пневмонію або менінгіт. Найгірше ускладнення – це відмова органів.
Лікарі закликають японців носити маски, оскільки хвороба передається повітряно-крапельним шляхом.

Medcentre.com.ua Медичний інформаційний ресурс
Medcentre.com.ua Медичний інформаційний ресурс 


Коментарі